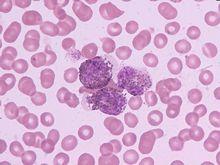
白血病

簡介
血液癌亦稱血癌(Leukemia),就是俗稱的「白血病」。
白血病
白血病觀察白血病年齡別發病率曲線,發現在5歲以下及15—20歲間有兩個小高峰,在40歲以後隨年齡增長發病率逐漸升高,高峰年齡在60歲以後。但各型白血病發病年齡不盡相同。根據調查發現白血病的發病率大城市高於農村,油田和污染地區的發病率明顯增高,男性略高於女性。就各型白血病來看急性多於慢性。根據我國1986—1988年調查資料,各型白血病的發病率以急非淋最高,其次為急淋、慢粒,慢淋和特殊類型最低。
血癌的診斷
血液檢查:白血球數目增高,可能增高到數十萬以上(但有少部份的病人反而減少白血球數目),且大量出現未成熟的白血球,其他如血紅素下降、紅血球數目減少,血小板數目減少等。
周邊血液抹片檢查:出現許多髓芽細胞,這些髓芽細胞就是不成熟的白血球。
骨髓穿刺切片檢查:骨髓穿刺的部位通常是抽取胸骨或骨盆腔處的腸骨脊,醫師會以穿刺針穿過皮膚,再以特殊的針鑽過骨頭表層,抵達骨髓腔,抽出少許骨髓血。骨髓切片做法同骨髓穿刺,只是使用的針為特殊的切片針,這兩項檢查可同時完成。
血癌的症狀
白血病人往往以感染髮熱為主要症狀,絕大多數患者血中的白細胞數是很高的,雖然白細胞數量很多,但它們都是些不成熟的幼稚的細胞,猶如一些"娃娃兵"根本沒有抵抗敵人的能力,故白血病人很容易被感染,如口腔、咽喉、耳鼻、肛門,皮膚等處受到侵犯可出現一些炎症變化,細菌毒力強的,進入血液還可成為"敗血症"危及生命。由於白血病人骨髓中製造大量不成熟的白細胞,而產生血小板的巨核細胞就明顯減少了,故白血病人可出現皮膚黏膜,多個組織器官的出血,嚴重的可發生顱內出血。白血病細胞侵犯到其他組織可表現為骨痛、骨膜上長瘤(絛色瘤)、皮膚結節、齒齦腫脹、肝脾淋巴結腫大等,還可表現為腦膜白血病,睪丸白血病等,白血病人多伴有貧血、又因出血而導致貧血加重。
急性白血病臨床表現
(一)白血病細胞浸潤影響正常造血細胞生成所表現的臨床症征:
1.發熱:是本病常見症狀。低熱多為本病發熱,高熱常為感染所致。感染髮生的部位通常為口腔、呼吸道、泌尿道、肛周及皮膚。
2.出血:可發生在周身任何部位的皮膚與黏膜,嚴重者可出現內臟大出血,甚至發生致命性顱內出血。
3.貧血:絕大多數患者有不同程度的貧血。表現為面色蒼白,頭暈乏力,心悸氣短等。
(二)白血病細胞浸潤骨髓以外器官出現的體徵:
1.肝、脾、淋巴結腫大:肝脾腫大是本病較常見的體徵,約占50%;淋巴結腫大可高達90%,以急淋為多見,其次為急單,再次為急粒。
2.骨及關節疼痛:胸骨壓痛是本病有診斷意義的體徵。疼痛的部位多發生在四肢骨及關節,呈遊走性,局部無紅、腫、熱現象。此外,少數年輕急粒患者之扁骨可出現綠色瘤,其特點為質硬並與骨膜相連,腫塊呈青色,皮薄處可呈綠色。
3.皮膚及五官表現:皮膚可見斑丘疹、結節、腫塊、皮炎等;齒齦腫脹出血,口腔潰瘍和咽痛,以急單為顯著。眼眶為綠色瘤多發部位,以突眼症為主要表現,重者可出現眼肌癱瘓失明。
4.其他:中樞神經系統由於浸潤及出血等可出現顱內壓增高及顱神經損害,外周神經也可可受累。心包膜、心肌及心內膜皆可被浸潤,但有臨床表現者較少見,可表現為心包積液、心率失常及心衰等。支氣管及肺亦可受到白血病細胞的浸潤。
血癌的治療
(1) 白血病化療
隨著白血病治療研究的進展,療效還在不斷提高。為根治白血病帶來了希望。為達此目的,必須根據每個病人的不同特點,綜合現代化治療手段,充分認識到白血病的治療是一個整體,特別要分析、認識每例病人自身的特點,如年齡、性別、白血病類型、血液學特徵、細胞遺傳學和分子生物學特徵、白血病細胞的細胞動力學等。在此基礎上為病人設計最佳的治療方案,合理利用現代化治療手段,如化療、造血幹細胞移植、生物及基因治療、中西醫結合治療等多種手段互相配合、相互協調,最大可能的避免各種毒副作用。殺滅白血病細胞,使病人達到長期存活乃至治癒的目的。
(2) 白血病中醫治療
從大量的臨床實踐來看,中醫、中藥人參皂苷rh2在白血病治療中儘早參與可明顯改善患者的病情。中醫對人體的調理是全面的,中醫對氣血、陰陽、臟腑的調理可以對應於西醫的免疫功能、免疫狀態的調節等,也就是說中醫對改善患者的生活質量有明顯優勢,因此,中醫、中藥的儘早參與對疾病的恢復非常有利。
血癌的治療方案
西黃丸+複方斑蝥膠囊
複方斑蝥膠囊+消癌平片
珍香膠囊+複方斑蝥膠囊
複方斑蝥膠囊+鴉膽子油口服液
參丹散結膠囊+西黃丸
驗方偏方
驗方:①125g重蟾蜍15隻(去內臟洗淨),黃酒1500ml。將黃酒蟾蜍共放入瓷罐中封閉,然後將瓷罐入鍋內加水蒸煮2小時·濾出藥液,備用。治療:成人每日3次,15—30ml/次,飯後用;兒童用量酌減。連服藥直至症狀完全緩解。其後維持治療,服藥半月,間歇半月。期間可套用其它支持療法。
療效:採用本方共治療各型白血病32例(服藥均達20天以上),總緩解率為75%,完全緩解率為25%。其中以急淋療效最好,完全緩解率為33.3%,總緩解率為88.6%。
方源:千家明等:中藥蟾蜍酒治療白血病——附32例療效觀察。《遼寧中醫》(4):18,1984。
②六神丸(市售):每日90—150粒(270—450mg),分3—4次服。
療效:治療白血病10例,其中CML7例,急性白血病3例。7例CML中1例完全緩解,1例部分緩解,5例進步。另3例急性白血病,1例AML完全緩解。
偏方:洗碗葉根3—6錢。水煎服,每日3次。
療效:治療1例慢粒,25天緩解。
方源:雲南中醫研究所。

